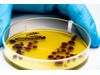

Green Solution Industries
- Home
- Companies
- Green Solution Industries
- Services
- Green Solution Laboratory - ...

Green Solution Laboratory - Model GS22_LT_Micro -Microbiological Testing Services in Maharashtra | Food, Water & Environment Testing by Green Solution Lab
Green Solution Lab offers reliable and accredited Microbiological Testing Services for Food, Water, Air, Pharma, Cosmetics, and Environmental samples. Based in Pune, Maharashtra, we serve industries across Mumbai, Navi Mumbai, Thane, Nagpur, Nashik, and all major cities with precise microbial analysis for safety, compliance, and quality assurance. Our NABL-compliant laboratory ensures accurate testing of microorganisms like bacteria, fungi, yeasts, and pathogens using validated methods. From Total Plate Count (TPC) to specific pathogen testing (E. coli, Salmonella, Coliforms, etc.), we help businesses meet BIS, FSSAI, IS, and ISO standards.Most popular related searches
microbiology testing
microbial limits test
E. Coli
plate count
surface swab
fecal Coliforms
Clostridium perfringens
total Coliforms
bulk sampling
microbiology analysis

- Drinking Water & Packaged Water
- Food & Beverage Products
Pharmaceuticals & Nutraceuticals
Cosmetics & Personal Care
Dairy & Meat Processing
Effluent & Wastewater Samples
Indoor Air, Surface Swab & Environment Hygiene
R&D and Stability Studies

- NABL-compliant Laboratory
Rapid Turnaround Time
ISO, BIS, FSSAI, WHO-GMP Standards Compliance
Certified Microbiologists & Trained Lab Technicians
Industry-Specific Reporting Formats
Affordable Pricing, Bulk Sample Discounts
Support for Regulatory Submissions & Product Development
- Total Plate Count (TPC)
Total Coliforms / Fecal Coliforms
E. coli, Salmonella, Shigella, Listeria
Yeast & Mold Count
Staphylococcus aureus
Clostridium perfringens
Pseudomonas aeruginosa
Microbial Limit Testing
Surface and Swab Monitoring
Antibiotic Residue & Preservative Challenge Testing